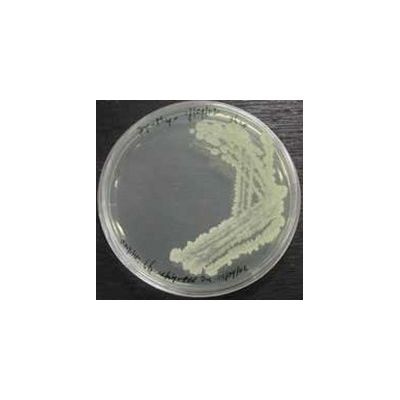

ARTECHNO SA
- Home
- Companies
- ARTECHNO SA
- Services
- Culture Media for Labs
Culture Media for Labs
FromARTECHNO SA
From its know-how in bacteria cultivation and in natural products, Artechno produces and distributes a range of culture media for microbe cultivation (bacteria, moulds, yeasts) or for cell cultivation. These media may serve for : water quality assessment, pharmaceutical industry assay media, food industry assay media, analysis of canned food, analysis of dairy products, analysis of frozen products, clinical assay media, Because of the risks due to the use of animal products for the production of other consumption products, Artechno developed a range of vegetable-extract-based culture media. It is the VEGETA product line, animal-product-free.
